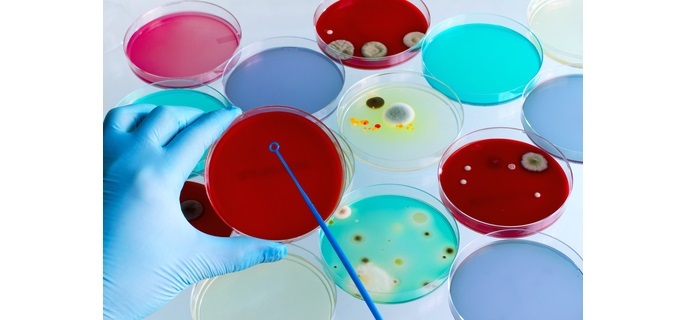

Article Categories
- All Categories
-
Data Structure
-
Networking
-
RDBMS
-
Operating System
-
Java
-
MS Excel
-
iOS
-
HTML
-
CSS
-
Android
-
Python
-
C Programming
-
C++
-
C#
-
MongoDB
-
MySQL
-
Javascript
-
PHP
-
Economics & Finance
Nutrient Media and Its Preparation
Introduction
Nutrient media is a type of growth medium that is commonly used in microbiology to culture and grow various microorganisms. It is a complex mixture of nutrients that are necessary for the growth of microorganisms such as bacteria, yeast, and fungi.

It can be made using a variety of different ingredients, each of which serves a specific purpose in promoting the growth of microorganisms. Discussed below are different types of nutrient media and their preparation.
Types of Nutrient Media
There are many different types of nutrient media that are used in microbiology, each of which is designed to meet specific requirements for the growth of microorganisms. Some of the most commonly used types of nutrient media include ?
Tryptic Soy Agar (TSA)
Tryptic soy agar (TSA) is a general-purpose medium that is commonly used in microbiology. It contains a mixture of peptone, soybean meal, and agar, which provides a rich source of nutrients for the growth of a wide range of microorganisms.

Blood Agar
Blood agar is a type of nutrient medium that contains sheep or horse blood. The blood provides a source of nutrients for the growth of fastidious microorganisms, which are those that require specific growth conditions in order to grow.
MacConkey Agar
MacConkey agar is a selective medium that is commonly used to isolate gram-negative bacteria. It contains bile salts, crystal violet, and lactose, which inhibit the growth of gram-positive bacteria and select for the growth of gram-negative bacteria.

Sabouraud Agar
Sabouraud agar is a selective medium that is commonly used to isolate fungi. It contains a low pH, which inhibits the growth of most bacteria and promotes the growth of fungi.
Components of Nutrient Media
The components of nutrient media can vary depending on the specific type of medium being used. However, there are some common components that are found in most types of nutrient media, including ?
Peptone: Peptone is a mixture of amino acids and short peptides that provide a source of nitrogen and carbon for the growth of microorganisms.
Beef Extract: Beef extract is a water-soluble extract of beef that provides a source of vitamins, minerals, and other nutrients that are necessary for the growth of microorganisms.
Agar: Agar is a gelling agent that is used to solidify nutrient media. It is derived from seaweed and is widely used in microbiology because it is stable at high temperatures and does not degrade over time.
Sodium Chloride: Sodium chloride is added to nutrient media to provide a source of ions that are necessary for the growth of microorganisms.
Lactose: Lactose is a type of sugar that is commonly used in selective media to select for the growth of specific microorganisms.
Preparing Nutrient Media
Preparing nutrient media is a critical step in microbiology, as it directly impacts the growth of microorganisms. The process of preparing nutrient media can vary depending on the specific type of medium being used, but generally involves the following steps ?
Weighing and Measuring
The first step in preparing nutrient media is to measure out the necessary ingredients. This typically involves weighing out the various powders and measuring out the appropriate volume of water.
Mixing and Heating
Once the ingredients have been measured out, they are mixed together in a flask or beaker. The mixture is then heated to dissolve the powders and sterilize the media.
Sterilization
Sterilization is a critical step in preparing nutrient media, as it ensures that the media is free from any contaminants that could interfere with the growth of microorganisms. There are several methods of sterilization that can be used, including autoclaving, filtration, and irradiation.
Autoclaving is the most commonly used method of sterilization and involves heating the media to a high temperature (usually around 121°C) for a specified amount of time (usually around 15-20 minutes). This kills any microorganisms that may be present in the media and ensures that the media is sterile.

Filtration can also be used to sterilize nutrient media, particularly for media that cannot be autoclaved. In this method, the media is passed through a filter with small pores that can trap any microorganisms present in the media.
Irradiation is another method of sterilization that involves exposing the media to gamma radiation. This method is less commonly used than autoclaving or filtration but can be useful for certain types of media.
Pouring and Cooling
Once the media has been sterilized, it is poured into Petri dishes or test tubes and allowed to cool and solidify. This creates a solid surface that microorganisms can grow on.
Inoculation
After the nutrient media has been prepared and solidified, it can be inoculated with microorganisms. This is typically done using a sterile loop or needle, which is used to transfer a small amount of the microorganism onto the surface of the media.
Incubation
Once the microorganisms have been inoculated onto the nutrient media, the Petri dishes or test tubes are placed into an incubator, which provides the appropriate temperature and conditions for the microorganisms to grow. Incubation times can vary depending on the type of microorganism being cultured and the specific nutrient media being used.
Conclusion
Nutrient media is a critical component of microbiology, providing the necessary nutrients and environment for the growth and study of microorganisms. The specific components and preparation methods of nutrient media can vary depending on the type of media being used and the microorganisms being cultured.
However, careful preparation and sterilization of nutrient media are essential for ensuring accurate and reliable results in microbiological experiments.
